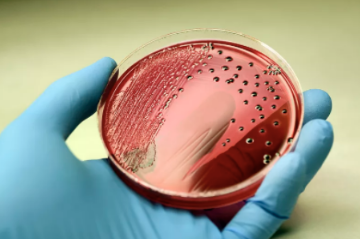

又又又见沙门菌
5月到6月国药东风总医院医学检验科微生物室总共鉴定出6例沙门菌,为什么这个季节沙门菌这么常见?沙门菌有那些危害以及怎么预防?我们需要着重认识下这个人畜共患的致病菌。
什么是沙门菌
沙门氏菌是一种人畜共患的肠道致病菌,以其发现者Daniel Elmer Salmon命名。在已知的2500多血清型中,有1400多种能感染人类。沙门氏菌广泛分布于自然界,且在自然界中生存力较强,在粪便、土壤、食品、水中可生存达5个月至2年之久。它在20℃以上即能大量繁殖,但对热抵抗力不强,到达60℃后,15分钟即可杀死。夏秋两季,是沙门氏菌一年中最活跃的时候。
感染沙门菌的主要临床症状
感染沙门氏菌的主要症状是发热、乏力、头痛腹泻等,还可伴有肌肉酸痛、视觉模糊、中等程度发热、躁动不安和嗜睡症状,症状通常持续2天~3天。虽然沙门氏菌通常能较快从肠道中消失,但约5%的病人在康复后会成为病原体的携带者。所有人都是沙门氏菌易感人群,少数小孩、老年人和免疫力较差的群体感染还可能出现危及生命的菌血症或脑膜炎等。

感染沙门菌的主要途径
沙门菌常常寄居于人和家禽、家畜的肠道中,主要靠污染的食品有肉、蛋、奶、及其制品等致病。据测算,我国每年因鸡肉导致的沙门氏菌食物中毒的发病人数达300多万人次,其中近半数与生鸡肉的交叉污染有关。主要原因是肉鸡中沙门氏菌污染率高,而我国居民厨房案板生熟分开的比例低(不足三成),未生熟分开的居民仅有半数用消毒剂清洗案板。如果居民都做到案板生熟分开,我国每年的沙门氏菌食物中毒人数可以减少200万人次;用消毒剂清洗案板,发病人数也可降低。

如何预防沙门菌感染
1购买检疫合格的禽、畜、蛋类食品,使用安全的饮用水和食物原料,降低食品中含有沙门氏菌的可能性;
2正确储存食品,在室温下,熟食存放的时间不要超过2小时,特别是高温高湿的天气;剩饭剩菜建议冷藏条件存放(2-8℃),并尽快食用,防止沙门氏菌繁殖;
3食物要烧熟煮透(尤其是禽类畜肉类和蛋类);
4注重厨房卫生,生熟砧板、刀具分开使用与存放,避免交叉污染;
5饭前便后勤洗手,防止携带者传染或自身反复感染。
上一篇: 呼吸道病毒检测知多少?
下一篇: 尿中出现蛋白一定就是肾病?




























 版权所有© 国药东风总医院
版权所有© 国药东风总医院  鄂公网安备 42030302000164号
鄂公网安备 42030302000164号